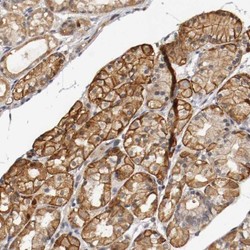

NBP1-88139
antibody from Novus Biologicals
Targeting: TNFRSF1B
CD120b, p75, TNF-R-II, TNF-R75, TNFBR, TNFR2, TNFR80
Antibody data
- Antibody Data
- Antigen structure
- References [3]
- Comments [0]
- Validations
- Western blot [1]
- Immunohistochemistry [5]
Submit
Validation data
Reference
Comment
Report error
- Product number
- NBP1-88139 - Provider product page

- Provider
- Novus Biologicals
- Proper citation
- Novus Cat#NBP1-88139, RRID:AB_11033809
- Product name
- Rabbit Polyclonal TNF RII/TNFRSF1B Antibody
- Antibody type
- Polyclonal
- Description
- Immunogen affinity purified. Specificity of human TNF RII/TNFRSF1B antibody verified on a Protein Array containing target protein plus 383 other non-specific proteins.
- Reactivity
- Human
- Host
- Rabbit
- Isotype
- IgG
- Vial size
- 0.1 ml
- Storage
- Store at 4C short term. Aliquot and store at -20C long term. Avoid freeze-thaw cycles.
Submitted references TNFR2+ TILs are significantly associated with improved survival in triple-negative breast cancer patients.
Affinity proteomics reveals elevated muscle proteins in plasma of children with cerebral malaria.
Variance decomposition of protein profiles from antibody arrays using a longitudinal twin model.
Dadiani M, Necula D, Kahana-Edwin S, Oren N, Baram T, Marin I, Morzaev-Sulzbach D, Pavlovski A, Balint-Lahat N, Anafi L, Wiemann S, Korner C, Gal-Yam EN, Avivi C, Kaufman B, Barshack I, Ben-Baruch A
Cancer immunology, immunotherapy : CII 2020 Jul;69(7):1315-1326
Cancer immunology, immunotherapy : CII 2020 Jul;69(7):1315-1326
Affinity proteomics reveals elevated muscle proteins in plasma of children with cerebral malaria.
Bachmann J, Burté F, Pramana S, Conte I, Brown BJ, Orimadegun AE, Ajetunmobi WA, Afolabi NK, Akinkunmi F, Omokhodion S, Akinbami FO, Shokunbi WA, Kampf C, Pawitan Y, Uhlén M, Sodeinde O, Schwenk JM, Wahlgren M, Fernandez-Reyes D, Nilsson P
PLoS pathogens 2014 Apr;10(4):e1004038
PLoS pathogens 2014 Apr;10(4):e1004038
Variance decomposition of protein profiles from antibody arrays using a longitudinal twin model.
Kato BS, Nicholson G, Neiman M, Rantalainen M, Holmes CC, Barrett A, Uhlén M, Nilsson P, Spector TD, Schwenk JM
Proteome science 2011 Nov 17;9:73
Proteome science 2011 Nov 17;9:73
No comments: Submit comment
Supportive validation
- Submitted by
- Novus Biologicals (provider)
- Main image

- Experimental details
- Western Blot: TNF RII/TNFRSF1B Antibody [NBP1-88139] - Analysis in human cell line CAPAN-2.
Supportive validation
- Submitted by
- Novus Biologicals (provider)
- Main image

- Experimental details
- Immunohistochemistry-Paraffin: TNF RII/TNFRSF1B Antibody [NBP1-88139] - Staining of human stomach shows positivity in plasma.
- Submitted by
- Novus Biologicals (provider)
- Main image
- Experimental details
- Immunohistochemistry-Paraffin: TNF RII/TNFRSF1B Antibody [NBP1-88139] - Staining of human stomach shows moderate membranous positivity in glandular cells.
- Submitted by
- Novus Biologicals (provider)
- Main image

- Experimental details
- Immunohistochemistry-Paraffin: TNF RII/TNFRSF1B Antibody [NBP1-88139] - Staining of human lymph node shows moderate membranous positivity in non-germinal center cells.
- Submitted by
- Novus Biologicals (provider)
- Main image

- Experimental details
- Immunohistochemistry-Paraffin: TNF RII/TNFRSF1B Antibody [NBP1-88139] - Staining of human liver shows moderate membranous positivity in hepatocytes.
- Submitted by
- Novus Biologicals (provider)
- Main image

- Experimental details
- Immunohistochemistry-Paraffin: TNF RII/TNFRSF1B Antibody [NBP1-88139] - Staining of human kidney shows moderate membranous positivity in cells in tubules.